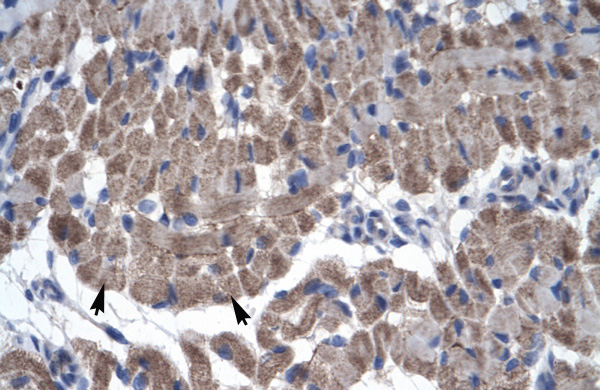

GAS7 antibody
| Product name: | GAS7 antibody |
| Source: | Rabbit |
| Purity: | >95% |
| Buffer Formulation: | phosphate buffered saline , pH 7.4, 150mM NaCl, 0.02% sodium azide and 50% glycerol. |
| Applications: | WB, IHC |
| Storage: | Aliquot and store at -20°C. Avoid repeated freeze / thaw cycles |
| UOM: | 100ug |
Rabbit anti-GAS7 polyclonal antibody - N-terminal region
Catalog Number:IC105093
Product Profile
| ProductName | Rabbit anti-GAS7 polyclonal antibody - N-terminal region |
|---|---|
| AntibodyType | Primary Antibodies |
| Immunogen |
The immunogen for anti-GAS7 antibody: synthetic peptide directed towards the N terminal of human GAS7 |
Key Feature
| Clonality | Polyclonal |
|---|---|
| Isotype | IgG |
| Host Species | Rabbit |
| Tested Applications | |
| Species Reactivity | |
| Concentration | 1mg/ml |
| Purification | Protein A |
Target Information
| GeneSymbol | GAS7 |
|---|---|
| GeneSynonyms |
GAS7
|
| Gene Full Name | Growth arrest-specific 7 |
| Gene Summary |
The growth arrest-specific 7 (GAS7) gene is expressed primarily in terminally differentiated brain cells and predominantly in mature cerebellar Purkinje neurons. GAS7 plays a putative role in neuronal development.
|
| AlternativeNames |
MLL/GAS7
|
| MolecularWeight(MW) | 54kDa |
| Sequence | 476 amino acids |
Database Links
| Entrez Gene | 8522 |
|---|---|
| SwissProt ID | Q7Z571 |
| Protein Accession | NP_958839 |
Application
-

Application
WB Suggested Anti-GAS7 Antibody Titration: 5.0ug/ml
ELISA Titer: 1:62500
Positive Control: Human cerebellum -
Application
Rabbit Anti-GAS7 Antibody
Catalog Number: ARP30004
Paraffin Embedded Tissue: Human Muscle
Cellular Data: Skeletal muscle cells
Antibody Concentration: 4.0-8.0 ug/ml
Magnification: 400X
Additional Information
| Form | Liquid |
|---|---|
| Storage Instructions | Aliquot and store at -20°C. Avoid repeated freeze / thaw cycles |
| Storage Buffer | phosphate buffered saline , pH 7.4, 150mM NaCl, 0.02% sodium azide and 50% glycerol. |
Note: The product is for research use only,not for use in diagnostic or therapeutic procedures.













